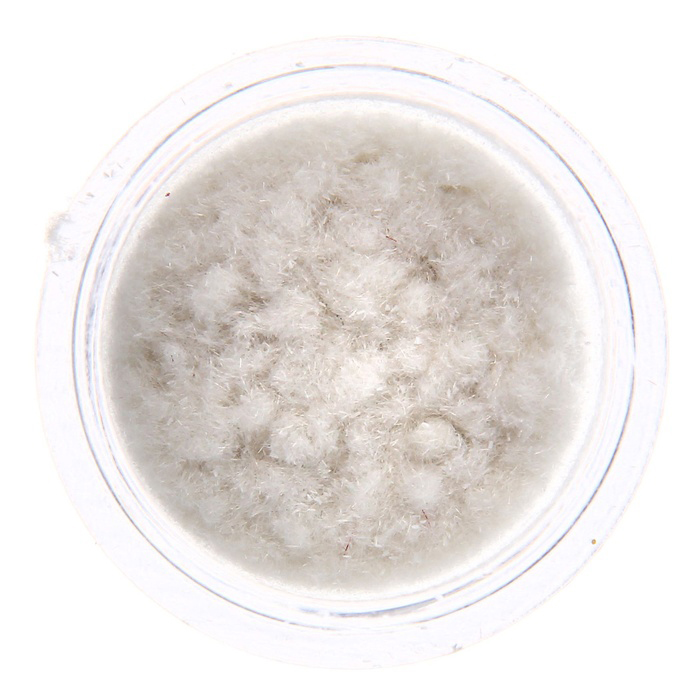
Флоковая пудра, цвет белый

24.02.2026
- В ПУТИ
- Бумага
- Мерч
- Картон/Кардсток
- Ткань, кожзам, замша
- Заготовки
- Украшения
- анкеры
- брадс
- люверсы
- конверты
- высечки/карточки/теги
- тканевые высечки
- вязаные/плетёные украшения
- наклейки/стикеры/декоративный скотч
- деревянные украшения
- декор из пластика/ гипса
- металлические украшения/подвески
- чипборд
- шейкеры
- топпинг/пайетки/бисер
- стразы/полубусины/дотсы
- пуговицы
- цветы/листья
- ленты/ тесьма/ кружево
- шнуры/верёвочки/проволока
- Расходные материалы
- Инструменты
- Фигурные дыроколы (компостеры)
- Вырубные станки, ножи, пластины
- Штампы
- Трафареты, маски
- Штемпельные подушечки
- Краски, мисты, пудры, блёстки, акценты
- Хранение
- Эмбоссинг
обратная
связь
связь
У Вас есть возможность высказать свое мнение о нашей работе.
Ни одно сообщение не останется без внимания.
Ваше мнение очень важно для нас!
Ни одно сообщение не останется без внимания.
Ваше мнение очень важно для нас!